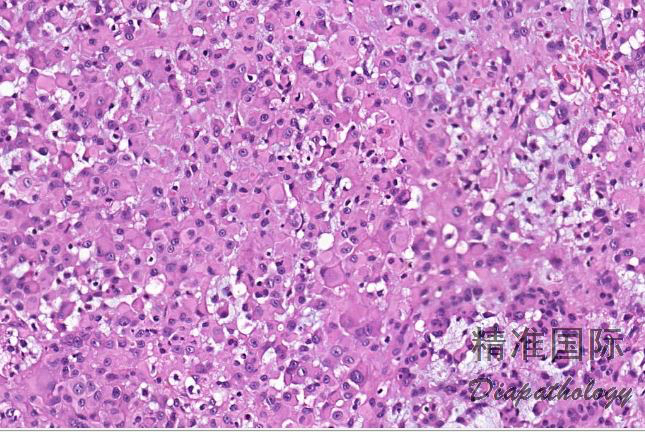
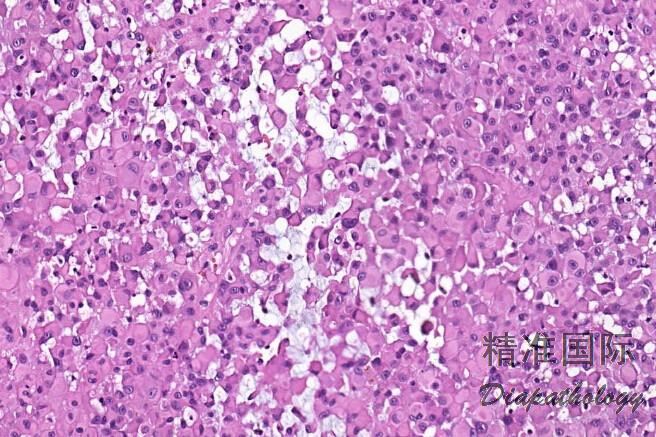
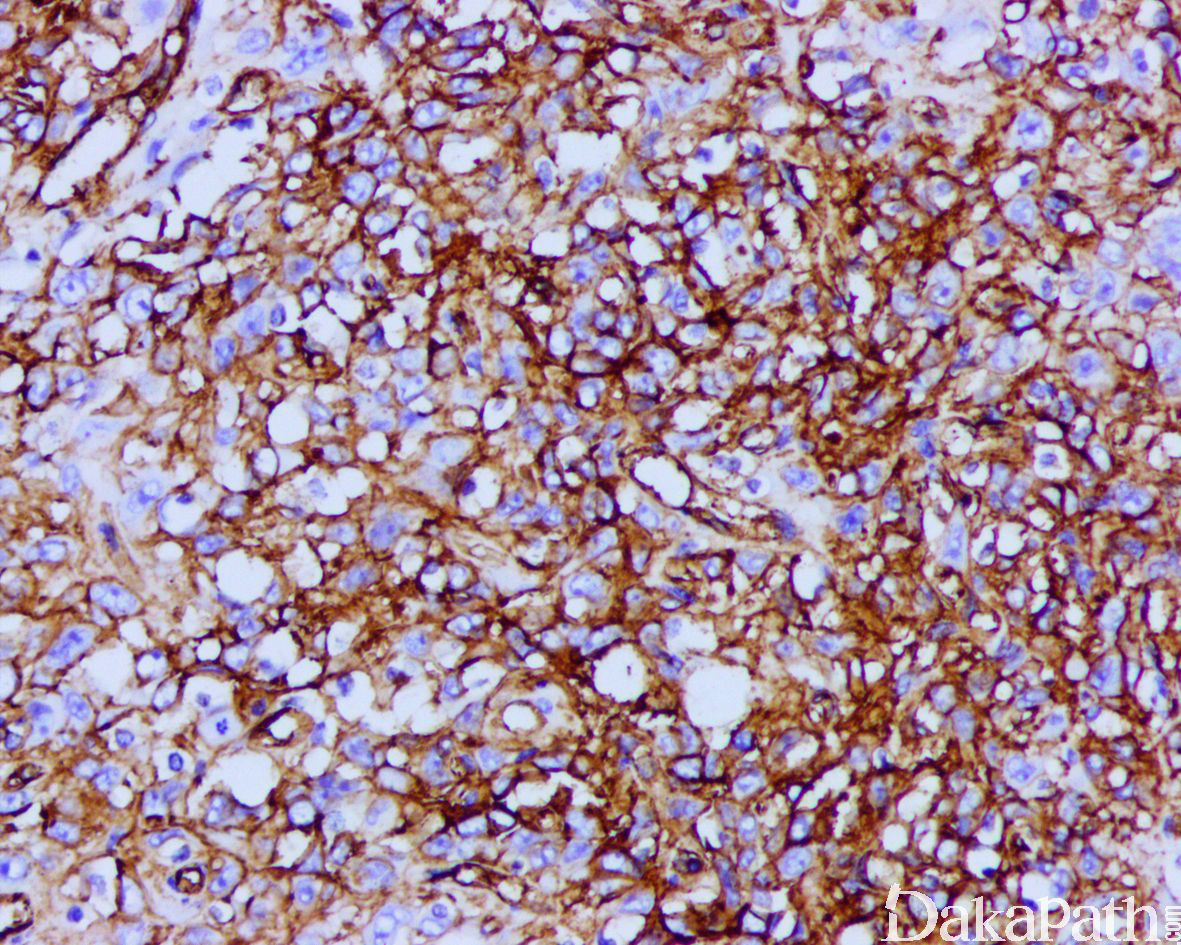

上皮样肉瘤
Epithelioid Sarcoma,ES
概述:
是一种瘤细胞分化方向尚不明确的恶性肿瘤,有 lNI1 缺失
发病部位: 四肢、躯干、头颈、盆腔
诊断要点:
临床上可分为经典型或远端型上皮样肉瘤和近端型上皮样肉瘤:
经典型或远端型上皮样肉瘤多发生于 10 ~ 39 岁的青少年,好发于手指、手、腕部和前臂的伸侧面,常有外伤史;多发生于浅表真皮或皮下;
近端型上皮样肉瘤(proximal-type) 多见于中年,好发于盆腔、会阴、肛旁、腹股沟、耻骨区、外生殖区等;主要表现为软组织深部肿块;
组织学上上皮样肉瘤由多边形上皮样细胞和多少不等的梭形细胞组成,根据形态不同可分为经典型、血管瘤样变型、纤维瘤样变型和近端型四种亚型。
经典型:
瘤细胞呈结节状或花环样排列,结节周围围绕胶原纤维,结节中央常伴有坏死;
肿瘤由上皮样细胞和梭形细胞共同组成,上皮样细胞呈多边形、卵圆形或胖梭形,胞质丰富,深嗜伊红色,和梭形细胞间有移行;细胞核轻度异型,呈空泡状,可见小核仁,核分裂像通常少于 5/10HPF;
间质可见嗜伊红色的胶原纤维;
少数病例可见钙化或骨化;
血管瘤样型:瘤细胞结节中央伴有明显的出血和囊性变,似扩张的血管;
纤维瘤样型:结节状排列不明显,以梭形细胞为主,细胞具有轻度核异型,瘤细胞之间可见较多的胶原纤维束;坏死少见;
近端型:
呈多结节性,以上皮样细胞为主,梭形细胞少;
上皮样细胞大而圆,有明显的异型性,染色质呈空泡状,可见明显的核仁,常见坏死;
部分区域可见横纹肌样瘤细胞,当横纹肌样瘤细胞较多时,可称为具有横纹肌样上皮样肉瘤。

免疫组织化学染色:
瘤细胞 AE1/AE3. EMA、CK8. CK19 和 vimentin 常阳性,50%-70%病例 CD34 阳性,95%以上显示 SMARCB1(INI1)表达丢失;部分病例可表达 MSA、α-SMA、S-100. ERG 和 NSE,偶尔表达 SALL4,—般不表达 CK20. desmin、NF、CEA 和 CD31。
分子标记:
95%以上可见 SMARCB1 基因缺失
鉴别诊断:
恶性黑色素瘤 :免疫组织化学染色 S-100. HMB45. SOX10. melan-A 常阳性,而 CK 和 EMA 多为阴性。
滑膜肉瘤:多发生于大关节附近,免疫组织化学染色 CK7 常阳性,CD34 为阴性,并具有特异性的 t(X;18)染色体异位。
炎性肉芽肿 :由多少不等的组织细胞、多核巨细胞和炎症细胞组成,细胞无异型性,间质水肿明显,并常见新生毛细血管。
环形肉芽肿:组织细胞呈栅栏状排列,中央有胶原变性,细胞异型性不明显,CK 阴性;
恶性横纹肌样瘤:与近端型上皮样肉瘤区别困难,两者具有相似的组织学和免疫表型特征包括 INI-1 表达缺失;与上皮样肉瘤不同,恶性横纹肌样瘤通常不表达 CD34, 不表达 ERG,多数表达 SALL4 可资鉴别。
假肌源性血管内皮细胞瘤:罕见坏死,瘤细胞具有横纹肌样特征,免疫组化染色表达上皮标志物和血管内皮标志物如 CD31,ERG,FLI-1 等,通常不表达 CD34。无 INI-1 表达缺失,遗传学上显示 FOSB 基因重排可与上皮样肉瘤区别;
7,上皮样血管肉瘤:无 INI-1 表达缺失,表达血管内皮细胞标志物如 CD31,ERG,FLI-1 等。
预后:
恶性,易复发及远处转移,局部复发率高达 77%,远处转移率可达 45%;
治疗:
根治性切除伴或不伴有淋巴结清扫;必要时需要截肢,术后可辅助放疗。
参考文献:
Hornick JL, Dal Cin P, Fletcher CD. Loss of INI1 expression is characteristic of both conventional and proximal-type
epithelioid sarcoma. Am J Surg Pathol. 2009;33:542–550. 王坚,朱雄增. 《软组织肿瘤病理学》(第二版),北京:人民卫生出版社,2017 年。
Kohashi K, Yamada Y, Hotokebuchi Y, et al. ERG and SALL4 expressions in SMARCB1/INI1-deficient tumors: a useful tool for distinguishing epithelioid sarcoma from malignant rhabdoid tumor[J]. Human Pathology, 2015, 46(2):225-230.
